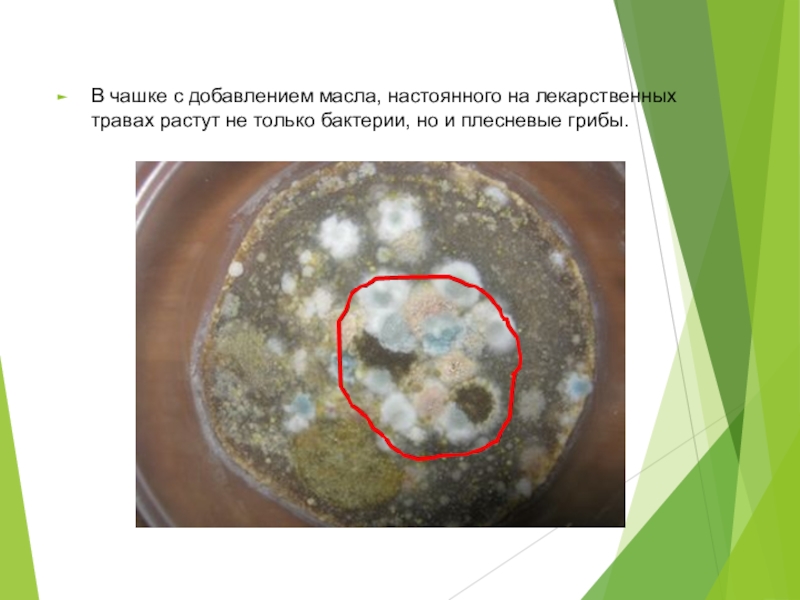

Авторы работы: Волкова Анастасия,
Бирюлина Вероника
Руководитель работы:
Кравцова Галина Ивановна
- Главная
- Разное
- Образование
- Спорт
- Естествознание
- Природоведение
- Религиоведение
- Французский язык
- Черчение
- Английский язык
- Астрономия
- Алгебра
- Биология
- География
- Геометрия
- Детские презентации
- Информатика
- История
- Литература
- Математика
- Музыка
- МХК
- Немецкий язык
- ОБЖ
- Обществознание
- Окружающий мир
- Педагогика
- Русский язык
- Технология
- Физика
- Философия
- Химия
- Шаблоны, фоны, картинки для презентаций
- Экология
- Экономика
Презентация, доклад по биологии Исследовательская работа
Содержание
- 1. Презентация по биологии Исследовательская работа
- 2. Цель нашего проекта: выявить причину влияния лука
- 3. Дома, на работе, на улице, в общественном
- 4. В нашем теле много микробов: в полости
- 5. Болезнетворными бактериями вызываются, например, такие заболевания, как
- 6. Вот перечень самых «грязных», густонаселенных бактериями предметов:-деревянная
- 7. Меры борьбы с бактериями:Влажная уборка, проветривание и
- 8. Изготовление питательной среды:
- 9. Чашка с лукомВ чашке с луком незначительное появление колоний было замечено на 6-ой день.
- 10. Питательная среда без добавления средств. Бактерии видны на 3-4 день.
- 11. В чашке с чесноком незначительные колонии бактерий начали появляться на 6-ой день
- 12. В чашке с антибиотиком на 3-4 день
- 13. В чашке с добавлением масла, настоянного на
- 14. Результаты эксперимента. Наиболее мощным антисептическим свойствам обладают
Цель нашего проекта: выявить причину влияния лука на ход заболевания.Задачи и этапы проекта: 1. Изучить микроорганизмы, вызывающие заболевания. 2. Изготовить питательную среду для микроорганизмов и проверить действие лука на бактерии. 3. Выявить другие
Слайд 1Исследовательский проект
"Фитонциды на страже нашего здоровья"
МБОУ «ООШ
село Красноармейское Калининского района Саратовской области»
Слайд 2Цель нашего проекта: выявить причину влияния лука на ход заболевания.
Задачи и
этапы проекта:
1. Изучить микроорганизмы, вызывающие заболевания.
2. Изготовить питательную среду для микроорганизмов и проверить действие лука на бактерии.
3. Выявить другие средства народной медицины, влияющие на рост и развитие бактерий.
1. Изучить микроорганизмы, вызывающие заболевания.
2. Изготовить питательную среду для микроорганизмов и проверить действие лука на бактерии.
3. Выявить другие средства народной медицины, влияющие на рост и развитие бактерий.
Слайд 3Дома, на работе, на улице, в общественном транспорте - везде нас
окружают бактерии, которые могут стать причиной многих заболеваний – патогенные бактерии.
Слайд 4В нашем теле много микробов: в полости рта и носа, в
глотке, в кишечнике.
Одни патогенные микроорганизмы вызывают заболевания, с которыми пораженный организм справляется сравнительно легко, другие - способны возбуждать тяжело протекающие и очень опасные болезни.
Одни патогенные микроорганизмы вызывают заболевания, с которыми пораженный организм справляется сравнительно легко, другие - способны возбуждать тяжело протекающие и очень опасные болезни.
Слайд 5Болезнетворными бактериями вызываются, например, такие заболевания, как ангина, туберкулез, возвратный тиф,
столбняк, гангрена, сибирская язва, бруцеллез, брюшной тиф, дизентерия, паратиф, ботулизм и т. д.
Слайд 6Вот перечень самых «грязных», густонаселенных бактериями предметов:
-деревянная кухонная доска;
-трубка телефона;
-губка для
мытья посуды;
-душевая занавеска;
-мусорные корзины в кухне и ванной;
-стиральная машина;
-компьютерный стол.
-душевая занавеска;
-мусорные корзины в кухне и ванной;
-стиральная машина;
-компьютерный стол.
Слайд 7Меры борьбы с бактериями:
Влажная уборка, проветривание и прогулки на свежем воздухе.
Мыть руки и поддерживать чистоту в ванной.
Дезинфицировать губку для мытья посуды в горячей воде с моющим средством.
При повреждении кожных покровов не надо промывать рану водой с мылом.
Кипятить питьевую воду.
Слайд 12В чашке с антибиотиком на 3-4 день бактерии появились вокруг места
нанесения антибиотика, а на 5-й день колонии разрастались и на месте нанесения антибиотика.
Слайд 13В чашке с добавлением масла, настоянного на лекарственных травах растут не
только бактерии, но и плесневые грибы.
Слайд 14Результаты эксперимента.
Наиболее мощным антисептическим свойствам обладают лук, чеснок. Благодаря фитонцидам,
выделяющимся из растения, лук и чеснок не только при контакте подавляют развитие бактерий, но и очищают окружающую атмосферу.
лук
чеснок
фурацилин
масло